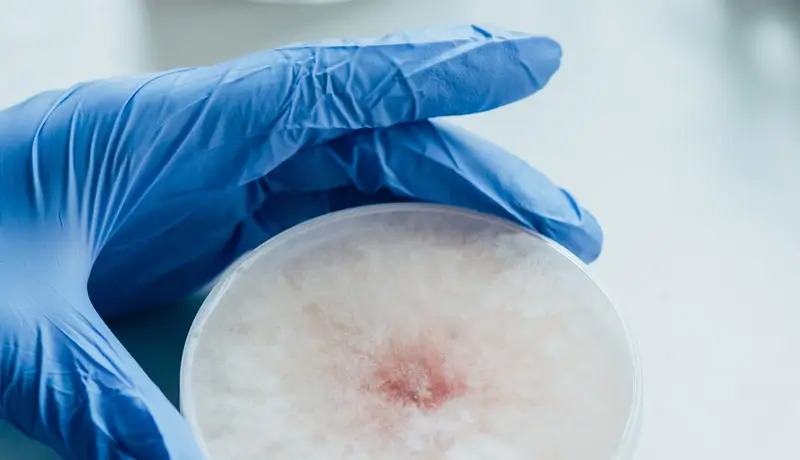
A gloved hand holding a petri dish with bacterial culture, representing laboratory analysis related to post-streptococcal glomerulonephritis (PSGN).

PSGN Causes and Treatment
Understanding Poststreptococcal Glomerulonephritis (PSGN): Causes, Symptoms, and Treatment
Poststreptococcal glomerulonephritis (PSGN) is a kidney condition that happens after an infection caused by group A streptococcal bacteria. It mostly affects children but can also impact adults. This condition often leads to a quick and severe decline in kidney function. PSGN typically follows a throat infection (like strep throat) or a skin infection (such as impetigo). Understanding its causes, symptoms, and treatment options is essential to ensure effective management.
What is Poststreptococcal Glomerulonephritis?
PSGN develops when the body’s immune system reacts to a strep infection and unintentionally damages the kidneys. During an infection, the immune system produces antibodies to fight the bacteria. These antibodies can form clusters that lodge in the kidneys, triggering inflammation and reducing their ability to filter waste from the blood. Improved hygiene and healthcare have made PSGN less common in developed countries, but it remains a significant issue in areas with limited medical access.
Causes of PSGN
The primary cause of PSGN is an infection with group A streptococcal bacteria. These bacteria can cause illnesses like strep throat and skin infections. PSGN usually appears as a delayed response to these infections. Key points include:
- Strep Throat: Symptoms of PSGN usually begin 1-2 weeks after a strep throat infection.

- Skin Infections: Conditions like impetigo can cause PSGN, with symptoms showing 3-6 weeks after the infection.
Poor hygiene, overcrowded living spaces, and limited healthcare access increase the risk of PSGN. These factors are more common in areas with lower socioeconomic conditions, making PSGN a global health concern.
Symptoms of PSGN
PSGN symptoms depend on the severity of the condition. Some people may not show any signs, while others experience the following:
- Blood in the urine: Urine may appear smoky or cola-colored.
- Reduced urine output: A significant decrease in urine production is common.
- Swelling: Puffiness around the eyes in the morning is frequent and may spread to the legs and abdomen.
- High blood pressure: Elevated blood pressure requires monitoring.
- Protein in urine: Tests may detect high protein levels, especially in severe cases.
How PSGN Develops
PSGN occurs as the immune system forms clusters of antibodies and bacterial fragments that lodge in the kidneys. This process includes:
- Immune complex formation: Antibodies and bacterial fragments combine and affect the kidneys.
- Complement activation: Reduced C3 complement levels are an important marker for PSGN.
- Inflammation: Swelling in the kidneys hinders their ability to filter blood, causing waste buildup.
How Doctors Diagnose PSGN
Doctors use clinical evaluations and lab tests to diagnose PSGN. Steps include:
- Blood tests: Elevated anti-streptolysin O (ASO) titers and low C3 levels are common indicators.
- Urine tests: These often reveal blood, protein, and red blood cell clusters.
- Kidney function tests: High blood urea nitrogen (BUN) and creatinine levels show reduced kidney function.

- Imaging: Ultrasounds or CT scans assess kidney size and structure.
- Biopsy: This test confirms the diagnosis in uncertain cases.
Treatment and Management of PSGN
Most children recover from PSGN within weeks, but treatment aims to manage symptoms and prevent complications.
Medications
- Antibiotics: Penicillin or other antibiotics treat remaining infections.

- Diuretics: These help control fluid retention and blood pressure.
- Antihypertensives: Medications like ACE inhibitors manage high blood pressure.
Supportive Care
- Low-sodium diet: Reducing salt helps lower swelling and fluid buildup.
- Fluid restriction: Limiting fluids eases the burden on kidneys.
- Rest: Adequate rest aids recovery.
For severe cases, dialysis may be required to manage waste and fluid levels until kidney function improves.
How to Prevent PSGN
Preventing PSGN involves reducing the spread of strep infections through:
- Good hygiene: Regular handwashing reduces infection risk.
- Prompt treatment: Early antibiotics for strep infections lower the risk of PSGN.
Summary
Poststreptococcal glomerulonephritis (PSGN) is a serious but manageable condition. Early recognition and proper care improve outcomes. Preventing strep infections through hygiene and timely treatment reduces the risk significantly.
Frequently Asked Questions
-
What are the long-term effects of PSGN on kidney health?
Long-term effects of PSGN can vary depending on the severity of the initial condition and the individual’s overall health. While most children recover completely, some may experience lingering issues such as mildly reduced kidney function or hypertension. Adults are at a higher risk for chronic kidney disease or long-term proteinuria, requiring ongoing medical monitoring. -
Can lifestyle changes reduce the risk of PSGN recurrence?
Although PSGN typically does not recur, adopting healthier lifestyle practices can help reduce the risk of streptococcal infections that might lead to complications. This includes maintaining proper hygiene, improving immune health through balanced nutrition, and avoiding overcrowded living conditions where infections are more easily spread. -
Are there specific tests to predict the risk of PSGN in high-risk populations?
There are no specific tests to predict PSGN; however, screening for strep infections in communities with high prevalence can help identify and treat infections early. Preventive strategies such as throat swabs for strep detection and public health initiatives to improve hygiene can be beneficial in high-risk areas.
PSGN causes and treatment

